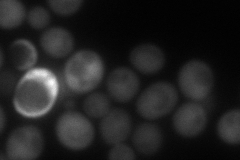
YMR138W
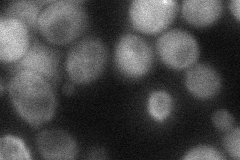
YMR138W
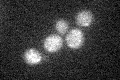
YMR138W
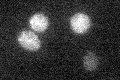
YMR138W

View description
GTP-binding protein involved in beta-tubulin (Tub2p) folding; isolated as mutant with increased chromosome loss and sensitivity to benomyl; regulated by the GTPase-activating protein, Cin2p, the human retinitis pigmentosa 2 (RP2) homolog
Localization:
Intensity:
Fold change:
Significance:
-
C’ GFP library in SD

below threshold17.07 -
N' NOP1pr-GFP in SD

cytosol74.2747 -
N' TEF2pr-mCherry in SD
cytosol100.411 -
N' NATIVEpr-GFP in SD

below threshold23.6147 -
N' TEF2pr-VC and Cyto-VN in SD
cytosol45.2866 -
C’ GFP library in SD+DTT

cytosol15.690.91No -
C’ GFP library in SD+H2O2
cytosol16.360.95No -
C’ GFP library in Starvation Media
cytosol16.330.95No -
C’ GFP library on the background of Pup2-DaMP

below threshold -
C’ GFP library on the background of CCT mutant

below threshold16.78790.982927No
